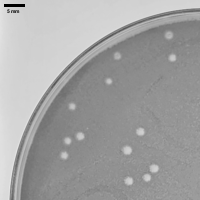
Jerma985 Plaque Picture Jerma985 Plaque Picture

Streptomyces phage Jerma985
Know something about this phage that we don't? Modify its data.
| Detailed Information for Phage Jerma985 | |
| Discovery Information | |
| Isolation Host | Streptomyces griseus ATCC 10137 |
| Found By | Ashkon Hazrati, Brian Pickard |
| Year Found | 2025 |
| Location Found | Bel Air, MD USA |
| Finding Institution | University of Maryland, Baltimore County |
| Program | Science Education Alliance-Phage Hunters Advancing Genomics and Evolutionary Science |
| From enriched soil sample? | No |
| Isolation Temperature | 30°C |
| GPS Coordinates | 39.521917 N, 76.292028 W Map |
| Discovery Notes | Collected in Bel Air, MD on Aug 31, 2025. Temperature: 77 F, soil was dry and loose, collected from a surface in a ditch along the side of the road. 1 day after a recent rainfall.. |
| Naming Notes | Named after Twitch Streamer "Jerma985" |
| Sequencing Information | |
| Sequencing Complete? | No |
| Genome length (bp) | Unknown |
| Character of genome ends | Unknown |
| Fasta file available? | No |
| Characterization | |
| Cluster | Unclustered |
| Subcluster | -- |
| Lysogeny Notes | Lysogeny test showed no meta cells after a week of incubation, most likely a virulent phage |
| Annotating Institution | Unknown or unassigned |
| Annotation Status | Not sequenced |
| Plaque Notes | Average diameter of 2.22mm, clear, somewhat rough edges, circular, small-moderate sizes. Grows in around 24-30 hours. |
| Morphotype | Siphoviridae |
| Has been Phamerated? | No |
| Publication Info | |
| Uploaded to GenBank? | No |
| GenBank Accession | None yet |
| Refseq Number | None yet |
| Archiving Info | |
| Archiving status | Not in Pitt Archives |
| Available Files | |
| Plaque Picture | Download |
| Restriction Digest Picture | Download |
| EM Picture | Download |